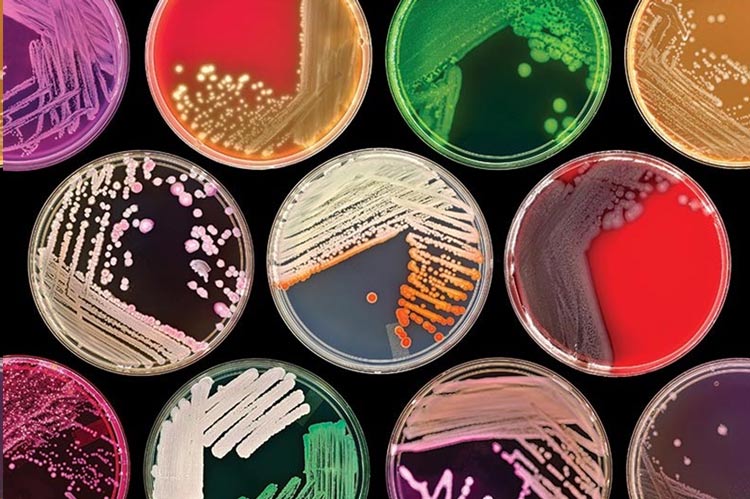
انواع محیط کشت

مقایسه انواع محیط کشت
شناخت انواع محیط کشت که به عنوان ابزار های اساسی در آزمایشگاههای میکروبی، برای رشد و تکثیر میکروارگانیسمها استفاده میشوند، امری حیاتی است. چرا که انتخاب محیط کشت مناسب بسته به نوع آزمایش، میکروارگانیسم های مورد نظر و هدف آزمایش میتواند تأثیر زیادی در دقت و صحت نتایج آزمایش ها داشته باشد. در این مقاله، به مقایسه انواع مختلف محیط کشت و کاربردهای آنها میپردازیم تا بتوانید انتخاب درستی برای آزمایشگاه خود داشته باشید.
انواع محیط کشت و مقایسه آنها
-
محیط کشت عمومی (General Purpose Media)
محیط کشت های عمومی مانند نوتریانت آگار (Nutrient Agar) و Tryptic Soy Agar (TSA) برای رشد اکثر باکتری ها و میکروارگانیسمها مناسب هستند. این محیطها در آزمایشگاهها برای کشت عمومی باکتریها و سایر میکروارگانیسمها کاربرد دارند و برای آزمایشهای اولیه میکروبی و شمارش میکروارگانیسمها استفاده میشوند.
مزایا:
- مناسب برای رشد انواع مختلف میکروارگانیسمها
- ساده و مقرون به صرفه برای آزمایشهای اولیه
- استفاده گسترده در آزمایشگاههای مختلف
معایب:
- برای شناسایی میکروارگانیسمهای خاص یا پیچیده مناسب نیست
برای آزمایشهایی مانند آزمون شمارش باکتریها که نیاز به محیط ساده و مؤثر دارند، استفاده از پتری دیشهای آماده مانند پتری دیش ۸ سانتیمتری یکبار مصرف میتواند گزینه مناسبی باشد.
-
محیط کشت انتخابی (Selective Media)
محیطهای کشت انتخابی بهگونهای طراحی شدهاند که فقط برخی از میکروارگانیسمها را میتوانند رشد دهند. این محیطها برای شناسایی و تفکیک باکتریهای خاص از سایر میکروارگانیسمها مفید هستند. بهعنوان مثال، محیط کشت مک کانکی آگار فقط به باکتریهای گرم منفی مانند اشریشیاکلی اجازه رشد میدهد و از رشد سایر باکتریها جلوگیری میکند.
مزایا:
- قابلیت شناسایی و تفکیک میکروارگانیسمهای خاص
- مناسب برای آزمایشهای انتخابی و شناسایی دقیقتر
معایب:
- تنها برای تعداد خاصی از میکروارگانیسمها کاربرد دارد
- برای استفاده عمومی مناسب نیست
برای آزمایشهایی مانند آزمونهای شناسایی باکتریهای خاص استفاده از محیط کشت انتخابی مانند مک کانکی آگار بسیار مناسب است. این محیط میتواند بهطور دقیقتر باکتریهای خاص را شناسایی کند.
-
محیط کشت تمایزی (Differential Media)
محیط کشت تمایزی به محیطهایی اطلاق میشود که قادر به تفکیک باکتریها بر اساس ویژگیهای متابولیکی یا بیوشیمیایی خاص آنها هستند. این ویژگیها میتوانند شامل تغییر رنگ محیط، تولید گاز، همولیز (شکست گلبولهای قرمز) یا تولید اسید از مواد موجود در محیط باشند. بهطور کلی، این محیطها برای شناسایی و تفکیک میکروارگانیسمها بهویژه زمانی که نیاز به شناسایی دقیقتری از باکتریها باشد، استفاده میشوند. بهعنوان مثال، محیط کشت بلاد آگار(BAP) برای شناسایی تفاوتهای متابولیکی در بین باکتریها استفاده میشود.
مزایا:
- شناسایی دقیقتر تفاوتهای بین میکروارگانیسمها
- کاربردهای خاص در شناسایی باکتریها و قارچها
معایب:
- نیاز به نظارت دقیقتر
- هزینه بیشتر نسبت به محیطهای کشت عمومی
این نوع محیط ها در آزمایشهایی مانند آزمون آنتی باکتریال بسیار مفید هستند. برای مثال، استفاده از بلاد آگار در شناسایی باکتریهای مولد همولیز از اهمیت ویژهای برخوردار است.
-
محیط کشت خاص (Specialized Media)
محیطهای کشت خاص مانند نامشان برای کشت میکروارگانیسمهای خاص طراحی شدهاند. این محیطها ممکن است برای رشد قارچها، مخمرها، یا حتی برای کشت سلولی استفاده شوند. بهعنوان مثال، محیط کشت SDAبرای کشت قارچها و مخمرها مناسب است. این محیطها بهویژه در آزمایشگاههای زیستفناوری، داروسازی و مطالعات سلولی کاربرد دارند.
مزایا:
- مناسب برای کشت انواع خاص میکروارگانیسمها
- بهینهسازی شرایط برای رشد ارگانیسم های خاص
معایب:
- برای آزمایشهای عمومی کاربرد ندارد
- هزینه بیشتر و نیاز به تجهیزات ویژه برای استفاده
انواع محیط کشت مانند SDAبرای آزمایشهای خاص قارچی یا محیط کشت سلولی برای کشت سلولهای انسانی و حیوانی کاربرد دارند. برای چنین آزمایشهایی، استفاده از پتری دیشهای شیشهای مانند پتری دیش شیشهای ۱۰ سانتیمتری که میتوانند استریل شده و دوباره استفاده شوند، توصیه میشود.
| مثالها | معایب | مزایا | ویژگیها | نوع محیط کشت |
| نوترینت آگار, TSA | برای شناسایی میکروارگانیسم های خاص محدود است. | ساده و مقرون به صرفه، مناسب برای رشد عمومی. | برای رشد انواع مختلف میکروارگانیسمها طراحی شده است. | محیط کشت عمومی |
| مک کانکی, محیط کشت گزیلور لیزین دوکسی کولات آگار | محدود به تعداد خاصی از میکروارگانیسمها. | شناسایی دقیقتر باکتری های خاص. | رشد فقط گروه خاصی از میکروارگانیسم ها را تسهیل میکند. | محیط کشت انتخابی |
| بلاد آگار, آگار EMB | ممکن است نیاز به بررسی دقیقتری داشته باشد | شناسایی و تفکیک باکتریها بر اساس ویژگیهای متابولیکی. | تفاوتهای ظاهری در رشد باکتریها را نشان میدهد (مثل تغییر رنگ). | محیط کشت تمایزی |
| آگار SDA | هزینه بالا و نیاز به تجهیزات خاص. | مناسب برای کشت میکروارگانیسم های خاص. | برای کشت ارگانیسم های خاص یا شرایط خاص طراحی شده است. | محیط کشت خاص |
در انتخاب انواع محیط کشت مناسب برای آزمایش های آزمایشگاهی، باید به نوع میکروارگانیسم های مورد نظر، هدف آزمایش و نیازهای خاص توجه داشته باشیم. برای آزمایش هایی که نیاز به رشد عمومی میکروارگانیسمها دارند، محیطهای کشت عمومی مانند کشت TSAیا نوترینت آگار مناسب خواهند بود. برای آزمایش های انتخابی یا شناسایی دقیقتر باکتریها، محیطهای کشت انتخابی و تمایزی مانند مک کانکی یا بلاد آگار انتخاب بهتری هستند. همچنین، در آزمایش های تخصصی مانند کشت سلولی یا قارچها، استفاده از محیط های کشت خاص و پتری دیش های شیشه ای یا قابل استفاده مجدد ضروری است.
سوالات متداول
۱. چرا باید از محیط کشت تمایزی در آزمون های آنتی باکتریال استفاده شود؟
محیطهای تمایزی به دلیل داشتن شاخصهای تغییر رنگ، تفکیک ویژگیهای متابولیکی یا آنزیمی باکتریها و امکان مشاهده واضح اثرات داروها، در آزمونهای آنتی‑باکتریال اهمیت دارند. این محیطها موجب میشوند که اثر آنتیبیوتیکها و تفاوت بین باکتریهای حساس یا مقاوم، با وضوح بیشتری دیده شود. برای مثال، محیطهایی مانند مولر هینتون آگار برای تست حساسیت آنتیبیوتیکی بهکار میروند
۲. تفاوت بین محیط کشت انتخابی، تمایزی و عمومی چیست؟
- انواع محیط کشت عمومی مانند TSA یا نوترینت آگار برای رشد گسترده میکروارگانیسمها طراحی شدهاند.
- انواع محیط کشت انتخابی میکروارگانیسم های خاص را ترجیح میدهد یا محدود به آنها میشود، مانند مک کانکی آگار که باکتریهای گرم منفی را هدف میگیرد.
- محیط کشت تمایزی قابلیت تفکیک بین میکروارگانیسمها را بر اساس ویژگیهای متابولیکی یا بیوشیمیایی فراهم میکند، مانند بلاد آگار که انواع همولیز در باکتریها را نشان میدهد
۳. آیا برای همه آزمونهای آنتی باکتریال باید محیطکشت تمایزی استفاده شود؟
خیر. برای آزمون هایی که فقط نیاز به رشد عمومی باکتریها دارند یا بررسی اولیه هستند، محیط کشت های عمومی کافی هستند. اما در آزمون هایی که هدف شناسایی باکتری های خاص، تفکیک آنها یا بررسی اثر دقیق داروها باشد، محیطکشت انتخابی یا تمایزی بسیار مؤثرتر هستند.
۴. چگونه محیط کشت مناسب برای آزمون خاص انتخاب کنیم؟
برای انتخاب محیطکشت مناسب، باید به این نکات توجه داشت: نوع باکتری (گرم مثبت، گرم منفی)، هدف آزمایش (رشد، شناسایی، حساسیت دارویی)، فرجه زمانی و هزینه. برای مثال در آزمونهای حساسیت دارویی معمولاً محیطهایی مانند مولر هینتون به دلیل ثبات و یکنواختی استفاده میشوند.
۵. آیا انتخاب محیط کشت نامناسب میتواند نتایج را تحت تأثیر قرار دهد؟
بله، انتخاب ظرف یا محیطکشت نامناسب ممکن است منجر به رشد ناقص میکروارگانیسمها، تفکیک ناصحیح یا مشاهده خطا شود. بنابراین انتخاب صحیح محیط کشت، به همراه ظروف مناسب مانند پلیت یکبار مصرف ۸ سانت، بخش اساسی هر آزمون میکروبی است.






